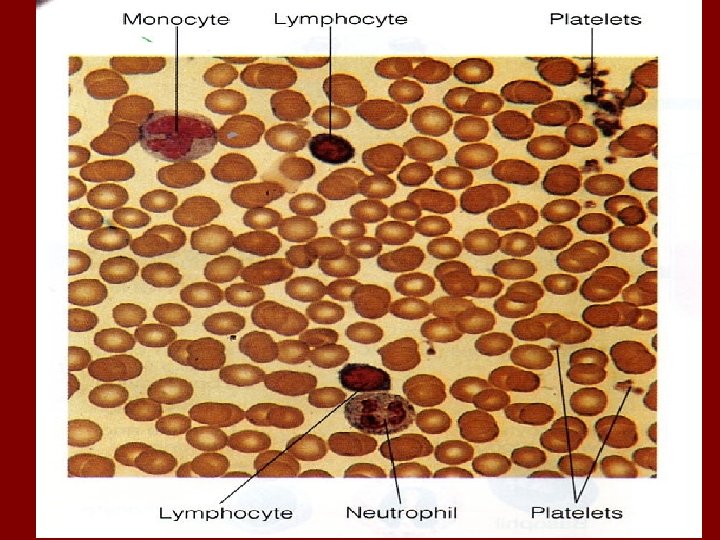

Blood Blood Whole Blood is classified as connective

Blood • Blood (Whole Blood): is classified as connective tissue! It consists of cells and cell fragments surrounded by a fluid matrix. • Formed Elements: cells and cell fragments (platelets) packets of cytoplasm critical for clotting. The cells are Red Blood Cells (RBC’s), or erythrocytes, transport carbon dioxide and oxygen. Less numerous White Blood Cells (WBC’s) or leukocytes, body’s defense mechanism. • Plasma: the liquid matrix of dissolved proteins, slightly denser than water. • Blood Volume: girls 4 to 5 L, boys 5 to 6 L, and is approximately 8% of the body’s total weight. • Collection: venipuncture, collection of venous blood from cubital vein for analysis, most common procedure. Arterial Stick, sample from the artery for blood gas evaluation.

Blood (cont. ) • Temperature: slightly hotter than body temp. 100. 4 F • Viscosity: 5 x more viscous (stickier) and more cohesive. • p. H: 7. 35 – 7. 45, venous is slightly lower than arterial.

Function of Blood • Transportation, Maintenance & Protection • Transportation of dissolved gases, nutrients, hormones, and metabolic wastes. • Regulation of p. H and ion composition of interstitial fluids throughout the body. • Restriction of fluid loss at injury sites. • Defense against toxins and pathogens. • Stabilization of body temperature.

Plasma • Pale yellow fluid, accounting for a little more than half the blood volume 55%. • 92% water, and about 8% dissolved or suspended molecules • Colloidal Solution; a solution whose particles are resistant to gravity. • Plasma proteins: Albumins, globulins and fibrinogens • Serum: plasma with the clotting factors removed. • Other Stuff: salts, nutrients, gases, wastes, hormones and enzymes. • Albumins: 60% of all plasma proteins, they contribute to the osmotic pressure of plasma. • Globulins: 35% plasma proteins, 1) antibodies (immunoglobulins) attack foreign proteins and pathogens. 2) transport proteins, carry hormones and compounds that might otherwise be lost in the kidney.

Plasma • Fibrinogens; blood clotting, by forming large insoluble strands of fibrin. • 1. 2. 3. 4. 5. 6. 7. Composition of Plasma Water 91. 5% Plasma Protein 7. 0% Ions 0. 9% Nutrients 0. 3% Gases 0. 1% Waste products 0. 1% Enzymes & hormones 0. 1%

Formed Elements • Highly specialized cells and cell fragments: 1. 2. Erythrocytes (RBC’s) 95% Leukocytes (WBC’s) 4%, only formed element with a nucleus Neutrophils Basophils Eosinophils Lymphocytes Monocytes 3. Thrombocytes (platelets) 1%

Formed Elements • Hemopoiesis (matopoiesis): red blood cell production. • Hemocytoblasts: the stem cells that give rise to various types of blood cells. • Types: proerythro, myelo, lympho, mono, and megakaryoblasts each of these is regulated by a specific growth factor. • Erythrocytes: most numerous formed elements, 5. 2 million per mm 3 in males and about 4. 5 million in females. It is a biconcave disk, this shape increases surface area for gas exchange. It can bend or fold in the center for easy passage in tight spaces. They have NO nucleus, and their primary component is a pigmented protein called Hemoglobin, fills a third of the cell and gives it, it’s red color. • Function: transport oxygen from the lungs to the body and carbon dioxide out.


Formed Elements (cont) • Hemolysis: rupture of red blood cells and Hgb released into the plasma. • Hemoglobin: consists of 4 protein chains and 4 heme groups. • Globin: protein that is bound to one Heme a red pigmented molecule with one Fe atom in the middle. Each of you contains about 4 grams of Fe, 2/3 of which is in the blood.


polycythemia • An excessive or abnormal increase in the number of erythrocytes • may result from bone marrow cancer • It may also be a normal physiological (homeostatic) response to living at high altitudes w / less oxygen available (2^polycythemia). • Causes increased blood viscosity, • flow sluggishly in the body and impairs circulation. •

Anemia types • Hemorrhagic – sudden hemorrhage • Hemolytic Lysis of RBCs due to bacterial infections • Pernicious Lack of vit. B 12 (Usually due to lack of intrinsic factor required for absorption of the vitamin. Intrinsic factor is formed by stomach mucosa cells. ) • Aplastic Depression/destruction of bone marrow by cancer, radiation, or certain medications • Iron deficiency diet or slow/prolonged bleeding (heavy menstrual flow or bleeding ulcer), which depletes iron reserves needed to make hemoglobin; RBCs are small and pale because they lack hemoglobin. – • Sickle cell anemia Genetic defect leads to abnormal hemoglobin, which becomes sharp and sickle shaped under conditions of increased oxygen use by body; occurs mainly in people of African descent

WBC’s • Leukocytes • less numerous than red blood cells, 1 percent of total blood volume • body defense against disease. • 4000 to 11, 000 WBCs per cubic millimeter, • only complete cells in blood; (nuclei and organelles) • protective, hitler was here. #NAZI 4 LYFE my defends the body against damage by bacteria, viruses, parasites, and tumors • diapedesis able to slip into and out of the blood vessels • chemotaxis WBCs locate tissue damage/Infection by responding to chemicals that diffuse from the damaged cells.

• • • Leukocytosis - total WBC count above 11, 000 cells/mm 3 the body speeds up their production due to disease indicates that a bacterial or viral infection is stewing in the body. leukopenia - is an abnormally low WBC count. caused by certain drugs, corticosteroids and anticancer agents. Leukocytosis is a normal and desirable re sponse to infectious threats to the body. By contrast, the excessive production of abnormal WBCs that occurs in infectious mononucleosis and leukemia is distinctly pathological. In • leukemia "white blood, " the bone marrow becomes cancerous, and huge numbers of immature WBCs incapable of protective functions. • Consequently, the body becomes the easy prey of disease causing bacteria

WBCs are classified into two major groups • Granulocytes are granule containing WBCs. They have lobed nuclei, which typically consist of several rounded nuclear areas connected by thin strands of nuclear material. The granules in their cytoplasm stain specifically with Wright's stain. • The granulocytes include the neutrophils , eosinophils, and basophils. • agranulocytes, lack visible cytoplasmic granules. Their nuclei are closer to the normal spherical, oval, or kidney shaped. • The agranulocytes include lymphocytes and monocytes


Hematopoiesis - Blood cell formation occurs in red bone marrow, the myeloid tissue in the flat bones of skull, pelvis, ribs, sternum • All the formed elements arise from one type of stem cell, the hemocytoblast. • The developmental process from hemocytoblast to mature RBC takes 3 to 5 days. • RBCs become rigid and fragment, or fall apart in 100 to 120 days. • erythropoietin controls rate of erythrocyte production (hormone) • colony stimulating factors (CSFs) and interleukins not only prompt red bone marrow to turn out leukocytes, but also enhance the ability of mature leukocytes to protect the body. • Thrombopoietin accelerates the production of platelets (hormone)

hemostasis (hem = blood; stasis = standing still), or stoppage of blood flow • This response, which is fast and localized, involves many substances normally present in plasma, as well as some that are released by platelets and injured tissue cells. • Hemostasis involves three phases, which occur in rapid sequence: • vascular spasms, • platelet plug formation, • coagulation, or clotting.

Undesirable Clotting • thrombus A clot that develops and persists in an unbroken blood vessel (coronary thrombosis), • embolus a thrombus breaks away from the vessel wall and floats freely in the bloodstream • Undesirable clotting may be caused by anything that roughens the endothelium of a blood vessel and encourages clinging of platelets, such as severe burns, physical blows, or an accumulation of fatty material. • Slowly flowing blood, or blood pooling, is another risk factor, especially in immobilized patients.

Bleeding Disorders • Thrombocytopenia - insufficient number of circulating platelets. Even normal movements cause spontaneous bleeding from small blood vessels. • It can arise from any condition that suppresses myeloid tissue, such as bone marrow cancer, radia tion, or certain drugs. • vitamin K is needed by the liver cells to produce clotting factors. • in hepatitis and cirrhosis, only whole blood transfusions are helpful. • hemophilia - several different hereditary bleeding disorders that result from a lack of any of the factors needed for clotting. • hemophiliacs are given a transfusion of fresh plasma or injections of the purified clotting factor they lack. • or genetically engineered clotting factors.

Blood groups and transfusions Losses of 15 to 30 percent lead to pallor and weakness. • • Losses of over 30 percent cause severe shock, which can be fatal. • treated blood can be stored (refrigerated at 4°C) for about 35 days until needed • Human Blood Groups • The plasma membranes of RBCs, like those of all body cells, bear genetically determined proteins (antigens), which identify each person as unique. • An antigen is a substance that the body recognizes as foreign and stimulates the immune system to release antibodies against it. • Most antigens are foreign proteins, that are part of viruses or bacteria • each of us tolerates our own cellular (self) antigens, • one person's RBC proteins will be recognized as foreign if transfused into another • The "recognizers" are antibodies present in the plasma that attach to RBCs bearing surface antigens different from those on the blood recipient's RBCs. • Binding of the antibodies causes the RBCs to clump, called agglutination* • There are over 30 common RBC antigens in humans, allowing each person's blood cells to be classified into different blood groups. However, it is the antigens of the ABO and Rh blood groups that cause the most vigorous transfusion reactions



• • The Rh blood groups are so named because one of the eight Rh antigens (agglutinogen D) was originally identified in Rhesus monkeys. Later the same antigen was discovered in human beings. Most Americans are Rh+ (Rh positive), meaning that their RBCs carry the Rh antigen. Unlike the an tibodies of the ABO system, anti Rh antibodies are not automatically formed and present in the blood of Rh~ (Rh negative) individuals. However, if an Rh" person receives mismatched blood (that is, Rh+), shortly after the transfusion his or her im mune system becomes sensitized and begins pro ducing antibodies (anti Rh+ antibodies) against the foreign blood type. Hemolysis (rupture of RBCs) does not occur with the first transfusion because it takes time for the body to react and start making antibodies. But the second time and every time thereafter, a typical transfusion reaction occurs in which the patient's antibodies attack and rupture the donor's RBCs. An important Rh related problem occurs in pregnant Rh~ women who are carrying Rh+ ba bies. Thefirst such pregnancy usually results in thedelivery of a healthy baby. Buc because the mother is sensitized by Rh+ antigens that have passed through the placenta into her bloodstream, she will form ; mti Rh+ antibodies unless treated with Rho. GAM shortly after giving birth. Rho. GAM is an immune serum that prevents this sensiti/ation and her subsequent immune response. If she is not treated and becomes pregnant again with an Rh+ baby, her antibodies will cross through the pla centa and destroy the baby's RBCs. producing a condition known as beinolytic disease of the new born. The baby is anemic and becomes hypoxic. Brain damage and even death may result unless fe tal transfusions are clone before birth to provide more RBCs for oxygen transport.
- Slides: 26